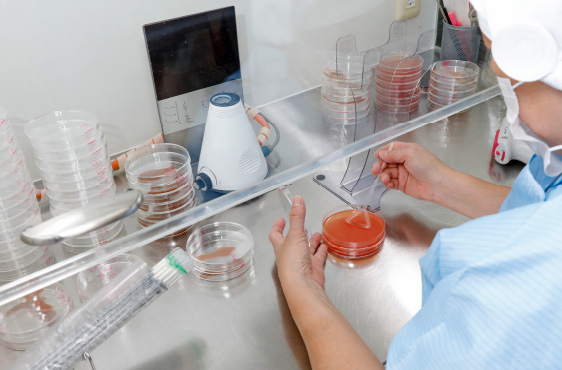

安心・安全をお届けするための取り組み
だれから見ても「安心・安全」な
製品・サービスをご提供します

SAFE
AND
SECURE
AND
SECURE
日々の積み重ねと継続こそが
「安心・安全」に繋がる
食品素材を製造する東京フードにとって最大のミッションは、安心・安全な製品・サービスを安定して提供することです。2016年には、食の安全の向上およびお客様からの信頼向上にむけて、食品安全に関する国際的な基準であるFSSC22000(食品安全)の認証を本社工場・第二工場にて取得しました。また、全部署から構成される「食品安全チーム」によりPDCAを回し、部署間でクロスチェックを行うなど、継続的に品質を高める取り組みを行っています。さらに、AIBを取り入れ、外部監査による客観的な評価によって「だれが見ても安心できる」環境を追求しています。このように、全社を挙げて、日々、安心・安全のための取り組みを行っています。

品質スローガン
食の安全 みんなの安心 しあわせつくる ものづくり
いばらきハサップ認定
| 認定機関 | 茨城県保健福祉部 生活衛生課 |
|---|---|
| 認定日 | 2011年8月29日 |
| いばらき食の安全情報WebSite | http://www.shoku.pref.ibaraki.jp/index.cgi |
| いばらきハサップ認証制度 | http://www.shoku.pref.ibaraki.jp/kanren_jigyosha/haccp/index.html |
FSSC22000:2005 認証取得
| 認定機関 | DNV・GL Business Assurance B.V., |
|---|---|
| 認定日 | 2016年8月29日(本社工場・第二工場) |
食品安全チームの活動
全社にわたる食品安全チームが中心となり、法令遵守、安心・安全な製品づくり、環境、
CSR(企業の社会的責任)等の継続的な改善を進め、よりよい企業を目指します。